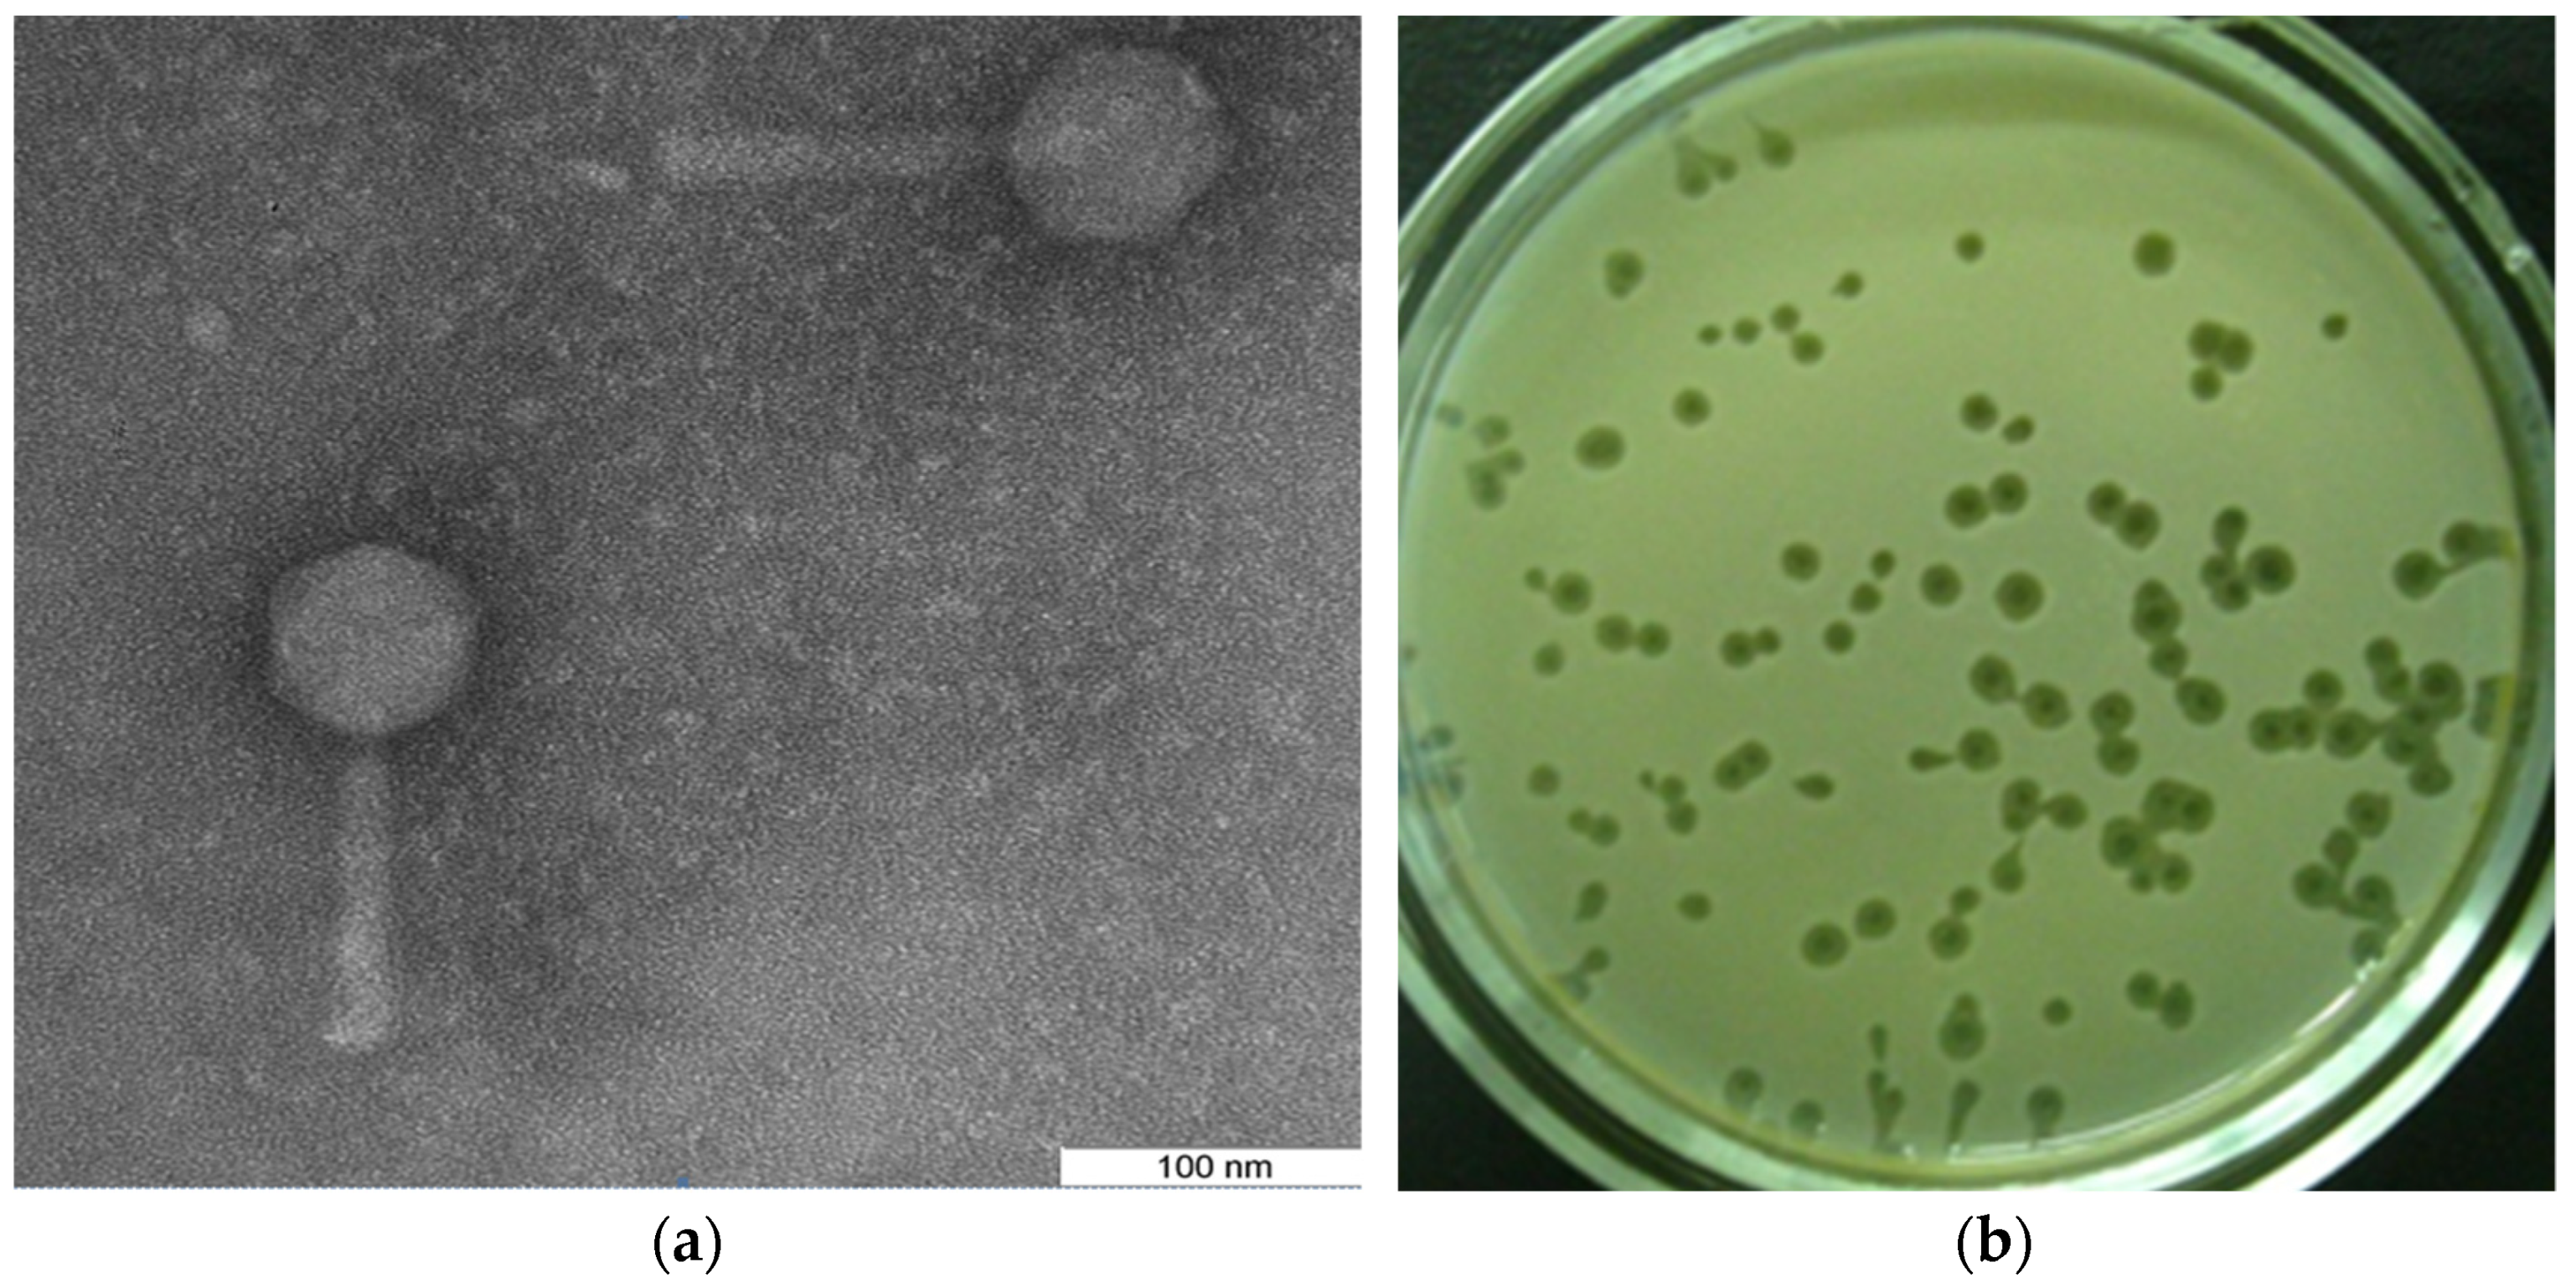
Mathematics 10 01925 g003

Multicompartmental Mathematical Model of SARS-CoV-2 Distribution in Human Organs and Their Treatment
Abstract
:1. Introduction
2. Materials and Methods
2.1. Mathematical Modeling

| Parameter | The Value | Units of Measure | References |
|---|---|---|---|
| 5.2 × 10−6 | (copies/mL)−1 × days−1 | [10] | |
| 5.2 × 10−6 | (copies/mL)−1 × days−1 | Assumption 1 [10,11,12] | |
| 5.2 × 10−6 | (copies/mL)−1 × days−1 | Assumption 1 [10,11,12] | |
| 4.0 | day−1 | [10] | |
| 5.0 | day−1 | Assumption 2 | |
| 1.0–2.0 | day−1 | Assumption 2 | |
| 0.23–0.93 | day−1 | [10] | |
| 0.46 | day−1 | [11] | |
| 0.046 | day−1 | [12] | |
| 100–100,000 | copies/mL | Assumption | |
| 0.05 | day | [13] | |
| 0.05 | day | [13] | |
| 0.05 | day | [13] | |
| 0.1 | day | Assumption | |
| 0.1 | day | Assumption | |
| 0.1 | day | Assumption | |
| 0.05 | day | Assumption | |
| 0.05 | day | Assumption | |
| 0.05 | day | Assumption | |
| 0.6 | day−1 | Assumption 3 [14] | |
| 0.03–0.00048 | day−1 | Assumption 3 experiment | |
| 0.03–0.0001 | day−1 | Assumption 3 experiment | |
| I | 0.3–0.8 | dimensionless | Assumption 4 |
| L | 0.8 | dimensionless | Assumption 4 |
| NP | 0.53–0.8 | dimensionless | Assumption |
| 0.5–0.995 | dimensionless | Assumption 4 | |
| 0.9–0.995 | dimensionless | Assumption 4 | |
| 0.7–0.995 | dimensionless | Assumption 4 | |
| 13 | day | [15] | |
| 8 | day | Assumption 4 | |
| 6 | day | [15] | |
| 1–14 | day | Assumption 4 | |
| 9 | day | Assumption 4 | |
| 1–7 | day | [15] |
2.2. Model Assumptions
2.3. Model Simulation and Sensitivity Analysis in BioUML
2.4. Mathematical Modeling of Sanitation with Virucidal Medications of the Nasopharynx and Intestines
2.5. Evaluation of the Transfer Efficiency of Model Viral Particles from the Nasopharynx to the Esophagus and Trachea, with Airborne Infection
2.6. Experimental Evaluation of the Efficiency of Viral Particles Transport from the Intestines to the Lungs through the Circulatory and Lymphatic Systems
2.7. Statistical Data Processing
3. Results
3.1. Viral Particles’ Distribution in Trachea, Lungs, and Esophagus after Airborne Infection
3.2. The Efficiency of the Viral Particles Transport from the Intestines to the Lungs
3.3. Model Simulations of SARS-CoV-2 Viral Dynamics and Distribution of the Viral Particles in Different Human Organs and Tissues
3.4. Sensitivity Analysis of the Model
3.5. Sanitation of the Intestines and Nasopharynx with Virucidal Drugs
4. Discussion
4.1. The Experimental Result by Using Bacteriophages
4.2. Model-Derived Results on the Viral Load Considering the Anatomical and Functional Relationships of the Organism Compartments
4.3. Model-Derived Results on the Viral Load Considering the Adaptive Immune Response and Virucidal Therapy
5. Conclusions
Supplementary Materials
Author Contributions
Funding
Institutional Review Board Statement
Informed Consent Statement
Data Availability Statement
Acknowledgments
Conflicts of Interest
References
- Huang, C.; Wang, Y.; Li, X.; Ren, L.; Zhao, J.; Hu, Y.; Zhang, L.; Fan, G.; Xu, J.; Gu, X.; et al. Clinical features of patients infected with 2019 novel coronavirus in Wuhan, China. Lancet 2020, 395, 497–506. [Google Scholar] [CrossRef] [Green Version]
- Guan, W.J.; Ni, Z.Y.; Hu, Y.; Liang, W.H.; Ou, C.Q.; He, J.X.; Liu, L. Clinical characteristics of coronavirus disease 2019 in China. N. Engl. J. Med. 2020, 382, 1708–1720. [Google Scholar] [CrossRef] [PubMed]
- Wolfel, R.; Corman, V.; Guggemos, W.; Seilmaier, M.; Zange, S.; Müller, M.; Niemeyer, D.; Jones, T.C.; Vollmar, P.; Rothe, C. Virological assessment of hospitalized cases of coronavirus disease 2019. medRxiv 2020. Available online: https://www.medrxiv.org/content/10.1101/2020.03.05.20030502v1 (accessed on 25 May 2022). [CrossRef] [Green Version]
- Sungnak, W.; Huang, N.; Bécavin, C.; Berg, M.; HCA Lung Biological Network. SARS-CoV-2 entry genes are most highly expressed in nasal goblet and ciliated cells within human airways. arXiv 2020. Available online: https://arxiv.org/abs/2003.06122 (accessed on 25 May 2022). [CrossRef] [Green Version]
- Schaefer, I.-M.; Padera, R.F.; Solomon, I.H.; Kanjilal, S.; Hammer, M.M.; Hornick, J.L.; Sholl, L.M. In situ detection of SARS-CoV-2 in lungs and airways of patients with COVID-19. Mod. Pathol. 2020, 33, 2104–2114. [Google Scholar] [CrossRef]
- Zheng, S.; Fan, J.; Yu, F.; Feng, B.; Lou, B.; Zou, Q.; Xie, G.; Lin, S.; Wang, R.; Yang, X.; et al. Viral load dynamics and disease severity in patients infected with SARS-CoV-2 in Zhejiang province, China, January–March 2020: Retrospective cohort study. BMJ 2020, 369, m1443. [Google Scholar] [CrossRef] [Green Version]
- Cole, P. Nasal and oral airflow resistors. Site, function, and assessment. Arch. Otolaryngol. Head Neck Surg. 1992, 118, 790–793. [Google Scholar] [CrossRef]
- Kolpakov, F.; Akberdin, I.; Kiselev, I.; Kolmykov, S.; Kondrakhin, Y.; Kulyashov, M.; Kutumova, E.; Pintus, S.; Ryabova, A.; Sharipov, R.; et al. BioUML: An integrated environment for systems biology and collaborative analysis of biomedical data. Nucleic Acids Res. 2022, gkac286. [Google Scholar] [CrossRef]
- Akberdin, I.R.; Kiselev, I.N.; Pintus, S.S.; Sharipov, R.N.; Vertyshev, A.Y.; Vinogradova, O.L.; Popov, D.V.; Kolpakov, F.A. A modular mathematical model of exercise-induced changes in metabolism, signaling, and gene expression in human skeletal muscle. Int. J. Mol. Sci. 2021, 22, 10353. [Google Scholar] [CrossRef]
- Kim, K.S.; Ejima, K.; Iwanami, S.; Fujita, Y.; Ohashi, H.; Koizumi, Y.; Asai, Y.; Nakaoka, S.; Watashi, K.; Aihara, K.; et al. A quantitative model used to compare within-host SARS-CoV-2; MERS-CoV, and SARS-CoV dynamics provides insights into the pathogenesis and treatment of SARS-CoV-2. PLoS Biol. 2021, 19, e3001128. [Google Scholar] [CrossRef]
- Bertalanffy, F.D. Respiratory tissue: Structure, histophysiology, cytodynamics. Part II. New approaches and interpretations. Tnt. Rev. Cytol. 1964, 17, 213–297. [Google Scholar] [CrossRef]
- Cheung, K.S.; Hung, I.F.N.; Chan, P.P.Y.; Lung, K.C.; Tso, E.; Liu, R.; Ng, Y.Y.; Chu, M.Y.; Chung, T.W.H.; Tam, A.R.; et al. Gastrointestinal manifestations of SARS-CoV-2 infection and virus load in fecal samples from the Hong Kong cohort and systematic review and meta-analysis. Gastroenterology 2020, 159, 81–95. [Google Scholar] [CrossRef] [PubMed]
- Wang, S.; Hao, M.; Pan, Z.; Lei, J.; Zou, X. Data-driven multi-scale mathematical modeling of SARS-CoV-2 infection reveals heterogeneity among COVID-19 patients. PLoS Comput. Biol. 2021, 17, e1009587. [Google Scholar] [CrossRef] [PubMed]
- Sun, Z.; Cai, X.; Gu, C.; Zhang, R.; Han, W.; Qian, Y.; Wang, Y.; Xu, W.; Wu, Y.; Cheng, X.; et al. Stability of the COVID-19 virus under wet, dry and acidic conditions. medRxiv 2020. Available online: https://www.medrxiv.org/content/10.1101/2020.04.09.20058875v1 (accessed on 25 May 2022). [CrossRef]
- MacLennan, I.C.; Gulbranson-Judge, A.; Toellner, K.M.; Casamayor-Palleja, M.; Sze, D.M.; Chan, E.Y.; Luther, S.A.; Orbea, H.A. The changing preference of T and B cells for partners as T-dependent antibody responses develop. Immunol. Rev. 1997, 156, 53–66. [Google Scholar] [CrossRef] [PubMed]
- Mygind, N.; Pedersen, M.; Nielsen, M. Morphology of the upper airway epithelium. In The Nose: Upper Airway Physiology and Atmospheric Environment; Proctor, D.F., Andersen, I., Eds.; Elsevier: New York, NY, USA, 1982; pp. 71–97. [Google Scholar]
- Fomin, V.M.; Ganimedov, V.L.; Melnikov, M.N.; Muchnaya, M.I.; Sadovsky, A.S.; Shepelenko, V.I. Numerical simulation of air flow in the human nasal cavity with imitation of the clinical method of the anterior active rhinomanometry. J. Appl. Mech. Tech. Phys. 2012, 53, 8–66. (In Russian) [Google Scholar] [CrossRef]
- Humphrey, S.P.; Williamson, R.T. A review of saliva: Normal composition, flow, and function. J. Prosthet. Dent. 2001, 85, 162–169. [Google Scholar] [CrossRef] [PubMed]
- Hui, K.; Cheung, M.C.; Perera, R.; Ng, K.C.; Bui, C.; Ho, J.; Ng, M.; Kuok, D.; Shih, K.C.; Tsao, S.W.; et al. Tropism, replication competence, and innate immune responses of the coronavirus SARS-CoV-2 in human respiratory tract and conjunctiva: An analysis in ex-vivo and in-vitro cultures. Lancet Resp. Med. 2020, 8, 687–695. [Google Scholar] [CrossRef]
- Toremalm, N.G. The daily amount of tracheobronchial secretions in man. Acta Otolaryng. 1960, 158, 43–53. [Google Scholar] [CrossRef]
- Openshaw, P. Crossing barriers: Infections of the lung and the gut. Mucosal Immunol. 2009, 2, 100–102. [Google Scholar] [CrossRef] [Green Version]
- Creamer, B.; Shorter, R.G.; Bamforth, J. The turnover and shedding of epithelial cells. Gut 1961, 2, 110–116. [Google Scholar] [CrossRef] [Green Version]
- Zuercher, A.W.; Coffin, S.E.; Thurnheer, M.C.; Fundova, P.; Cebra, J.J. Nasal-Associated Lymphoid Tissue Is a Mucosal Inductive Site for Virus-Specific Humoral and Cellular Immune Responses. J. Immunol. 2002, 168, 1796–1803. [Google Scholar] [CrossRef] [PubMed]
- Lauer, S.A.; Kyra, H.G.; Bi, Q.; Jones, F.K.; Zheng, Q.; Meredith, H.R.; Azman, A.S.; Reich, N.G.; Lessler, J. The Incubation Period of Coronavirus Disease 2019 (COVID-19) From Publicly Reported Confirmed Cases: Estimation and Application. Ann. Intern. Med. 2020, 172, 577–582. [Google Scholar] [CrossRef] [PubMed] [Green Version]
- Miao, H.; Hollenbaugh, J.A.; Zand, M.S.; Holden-Wiltse, J.; Mosmann, T.R.; Perelson, A.S.; Wu, H.; Topham, D.J. Quantifying the early immune response and adaptive immune response kinetics in mice infected with influenza A virus. J. Virol. 2010, 84, 6687–6698. [Google Scholar] [CrossRef] [Green Version]
- Mayer, A.; Zhang, Y.; Perelson, A.S.; Wingreen, N.S. Regulation of T cell expansion by antigen presentation dynamics. Proc. Natl. Acad. Sci. USA 2019, 116, 5914–5919. [Google Scholar] [CrossRef] [Green Version]
- To, K.K.; Tsang, O.T.; Leung, W.S.; Tam, A.R.; Wu, T.C.; Lung, D.C.; Yip, C.C.; Cai, J.P.; Chan, J.M.; Chik, T.S.; et al. Temporal profiles of viral load in posterior oropharyngeal saliva samples and serum antibody responses during infection by SARS-CoV-2: An observational cohort study. Lancet Infect. Dis. 2020, 20, 565–574. [Google Scholar] [CrossRef] [Green Version]
- Aktas, B.; Aslim, B. Gut-lung axis and dysbiosis in COVID-19. Turk. J. Biol. 2020, 44, 265–272. [Google Scholar] [CrossRef]
- Maghool, F.; Valiani, A.; Safari, T.; Emami, M.H.; Mohammadzadeh, S. Gastrointestinal and renal complications in SARS-CoV-2-infected patients: Role of immune system. Scand. J. Immunol. 2021, 93, e12999. [Google Scholar] [CrossRef]
- Rabitz, H.; Kramer, M.; Dacol, D. Sensitivity analysis in chemical kinetics. Annu. Rev. Phys. Chem. 1983, 34, 419–461. [Google Scholar] [CrossRef]
- Turgeon, N.; Toulouse, M.J.; Martel, B.; Moineau, S.; Duchaine, C. Comparison of Five Bacteriophages as Models for Viral Aerosol Studies. Appl. Environ. Microbiol. 2014, 80, 42–50. [Google Scholar] [CrossRef] [Green Version]
- Кoзлoва, Ю.Н.; Репин, В.Е.; Майбoрoдин, И.В. Treatment of the Surgical Infection Caused Pseudomonas Aeruginosa in Experiment. J. Exp. Clin. Surg. 2013, 6, 425–431. [Google Scholar] [CrossRef]
- Davydova, N.V.; Koptev, V.Y.; Kozlova, Y.N.; Sulimova, L.I.; Afonyushkin, V.N.; Cherepushkina, V.S. Estimation of permeability to bacteriophages of intestinal mucosa of chickens with eimeriosis. Sib. Her. Agric. Sci. 2019, 49, 57–63. [Google Scholar] [CrossRef]
- Xiao, F.; Tang, M.; Zheng, X.; Liu, Y.; Li, X.; Shan, H. Evidence for gastrointestinal infection of SARS-CoV-2. Gastroenterology 2020, 158, 1831–1833. [Google Scholar] [CrossRef] [PubMed]
- Hui, K.P.Y.; Ho, J.C.W.; Cheung, M.-C.; Ng, K.-C.; Ching, R.H.H.; Lai, K.-L.; Kam, T.T.; Gu, H.; Sit, K.-Y.; Hsin, M.K.Y.; et al. SARS-CoV-2 Omicron variant replication in human bronchus and lung ex vivo. Nature 2022, 603, 715–720. [Google Scholar] [CrossRef] [PubMed]
- Zhu, J.; Guo, J.; Xu, Y.; Chen, X. Viral dynamics of SARS-CoV-2 in saliva from infected patients. J. Infect. 2020, 81, e48–e50. [Google Scholar] [CrossRef]
- Wang, D.; Hu, B.; Hu, C.; Zhu, F.; Liu, X.; Zhang, J.; Wang, B.; Xiang, H.; Cheng, Z.; Xiong, Y.; et al. Clinical characteristics of 138 hospitalized patients with 2019 Novel Coronavirus-infected Pneumonia in Wuhan, China. JAMA 2020, 323, 1061–1069. [Google Scholar] [CrossRef]
- Gu, J.; Han, B.; Wang, J. COVID-19: Gastrointestinal manifestations and potential fecal–oral transmission. Gastroenterology 2020, 158, 1518–1519. [Google Scholar] [CrossRef]
- Mönkemüller, K.; Fry, L.; Rickes, S. COVID-19, coronavirus, SARS-CoV-2 and the small bowel. Rev. Esp. Enferm. Dig. 2020, 112, 383–388. [Google Scholar] [CrossRef]
- Pan, L.; Mu, M.I.; Yang, P.; Sun, Y.; Wang, R.; Yan, J.; Li, P.; Hu, B.; Wang, J.; Hu, C.; et al. Clinical characteristics of COVID-19 patients with digestive symptoms in Hubei, China: A descriptive, cross-sectional, multicenter study. Am. J. Gastroenterol. 2020, 115, 766–773. [Google Scholar] [CrossRef]
- Wu, Y.; Guo, C.; Tang, L.; Hong, Z.; Zhou, J.; Dong, X.; Yin, H.; Xiao, Q.; Tang, Y.; Qu, X.; et al. Prolonged presence of SARS-CoV-2 viral RNA in Faecal samples. Lancet Gastroenterol. Hepatol. 2020, 5, 434–435. [Google Scholar] [CrossRef]
- Natarajan, A.; Zlitni, S.; Brooks, E.F.; Vance, S.E.; Dahlen, A.; Hedlin, H.; Park, R.M.; Han, A.; Schmidtke, D.T.; Verma, R.; et al. Gastrointestinal symptoms and fecal shedding of SARS-CoV-2 RNA suggest prolonged gastrointestinal infection. Med 2022, in press. Available online: https://www.sciencedirect.com/science/article/pii/S2666634022001672 (accessed on 25 May 2022). [CrossRef]
- Zollner, A.; Koch, R.; Jukic, A.; Pfister, A.; Meyer, M.; Rossler, A.; Kimpel, J.; Adolph, T.E.; Tilg, H. Post-acute COVID-19 is characterized by gut viral antigen persistence in inflammatory bowel diseases. Gastroenterology 2022, in press. [CrossRef]
- Jones, D.L.; Baluja, M.Q.; Graham, D.W.; Corbishley, A.; McDonald, J.E.; Malham, S.K.; Hillary, L.; Connor, T.R.; Gaze, W.H.; Moura, I.B.; et al. Shedding of SARS-CoV-2 in feces and urine and its potential role in person-to-person transmission and the environment-based spread of COVID-19. Sci. Total Environ. 2020, 749, 141364. [Google Scholar] [CrossRef] [PubMed]
- Mesoraca, A.; Margiotti, K.; Viola, A.; Cima, A.; Sparacino, D.; Giorlandino, C. Evaluation of SARS-CoV-2 viral RNA in fecal samples. Virol. J. 2020, 17, 86. [Google Scholar] [CrossRef] [PubMed]
- Chan, P.K.; To, K.F.; Lo, A.W.; Cheung, J.L.; Chu, I.; Au, F.W.; Tong, J.H.; Tam, J.S.; Sung, J.J.; Ng, H.K. Persistent infection of SARS coronavirus in colonic cells in vitro. J. Med. Virol. 2004, 74, 1–7. [Google Scholar] [CrossRef]
- Sender, R.; Bar-On, Y.M.; Gleizer, S.; Bernshtein, B.; Flamholz, A.; Phillips, R.; Milo, R. The total number and mass of SARS-CoV-2 virions. Proc. Natl. Acad. Sci. USA 2021, 118, e2024815118. [Google Scholar] [CrossRef]
- Chua, R.L.; Lukassen, S.; Trump, S.; Hennig, B.P.; Wendisch, D.; Pott, F.; Debnath, O.; Thürmann, L.; Kurth, F.; Völker, M.T.; et al. COVID-19 severity correlates with airway epithelium–immune cell interactions identified by single-cell analysis. Nat. Biotechnol. 2020, 38, 970–979. [Google Scholar] [CrossRef]
- Mironova, T.E.; Afonyushkin, V.N.; Kozlova, Y.N.; Bobikova, A.S.; Koptev, V.Y.; Cherepushkina, V.S.; Sigareva, N.A.; Kolpakov, F.A. Study of the protective effects of virucidal drugs on the model of coronavirus pneumonia. Vet. Med. Feed. 2020, 7, 35–38. [Google Scholar] [CrossRef]
- Nefedova, E.; Koptev, V.; Bobikova, A.S.; Cherepushkina, V.; Mironova, T.; Afonyushkin, V.; Shkil, N.; Donchenko, N.; Kozlova, Y.; Sigareva, N.; et al. The Infectious Bronchitis Coronavirus Pneumonia Model Presenting a Novel Insight for the SARS-CoV-2 Dissemination Route. Vet. Sci. 2021, 8, 239. [Google Scholar] [CrossRef]
- Afonyushkin, V.N.; Cherepushkina, V.S.; Tatarchuk, O.P.; Frolova, O.A. Study of anti-phage activity of disinfectants as a factor of suppressing horizontal gene transfer. Bull. KSAU 2020, 4, 88–96. [Google Scholar] [CrossRef]
- Afonyushkin, V.N.; Shirshova, A.N.; Shamovskaya, D.V.; Plomodyalov, D.N. A study of the antiviral effect of drug triviron on IBV. Vet. Sci. 2018, 7, 24–28. [Google Scholar]
- Romo-Quiñonez, C.R.; Álvarez-Sánchez, A.R.; Álvarez-Ruiz, P.; Chávez-Sánchez, M.C.; Bogdanchikova, N.; Pestryakov, A.; Mejia-Ruiz, C.H. Evaluation of a new Argovit as an antiviral agent included in feed to protect the shrimp Litopenaeus vannamei against White Spot Syndrome Virus infection. PeerJ 2020, 8, e8446. [Google Scholar] [CrossRef] [Green Version]

| The Duration of the Experiment | 1 h | 2 h 30 min | ||||
|---|---|---|---|---|---|---|
| Organs | Lung | Trachea | Esophagus | Lung | Trachea | Esophagus |
| М ± SD | 5.502 ± 0.403 | 4.282 ± 0.19 | 3.269 ± 0.587 | 5.116 ± 0.406 | 3.672 ± 0.407 | 3.279 ± 0.348 |
| Shapiro–Wilk W | 0.8533 | 0.892 | 0.8145 | 0.7496 | 0.9172 | 0.76 |
| CI 95% | 5.03–5.98 | 4.05–4.51 | 2.58–3.96 | 4.64–5.6 | 3.19–4.15 | 2.85–3.67 |
| p-value (Mann–Whitney) | 0.292 | 0.019 | 0.629 | |||
| Dose of the Infection, Log10 PFU | Control | Case 1 | Case 2 | ||||||
|---|---|---|---|---|---|---|---|---|---|
| Nasopharynx | Intestine | Lungs | Nasopharynx | Intestine | Lungs | Nasopharynx | Intestine | Lungs | |
| 1.69 | 5.5 | 5.75 | 4.75 | 3.7 | 5.7 | 4.7 | 3.7 | 5.5 | 4.25 |
| 1.8 | 5.5 | 5.75 | 4.75 | 3.5 | 5.7 | 4.75 | 3.9 | 5.5 | 4.3 |
| 2 | 5.5 | 5.8 | 4.8 | 3.2 | 5.8 | 4.75 | 4 | 5.5 | 4.35 |
| 2.69 | 5.5 | 5.8 | 4.85 | 4.8 | 5.85 | 4.8 | 4.6 | 5.7 | 4.7 |
| 2.8 | 5.51 | 5.8 | 4.85 | 4.6 | 5.85 | 4.8 | 4.6 | 5.7 | 4.75 |
| 3 | 5.5 | 5.8 | 4.9 | 4.25 | 5.85 | 4.8 | 4.7 | 5.75 | 4.8 |
| 3.69 | 5.51 | 5.8 | 5 | 4.8 | 5.85 | 4.8 | 4.7 | 4.7 | 4.8 |
| M | 5.50 | 5.79 | 4.84 | 4.12 | 5.80 | 4.77 | 4.31 | 5.48 | 4.56 |
| SD | 0.00 | 0.02 | 0.09 | 0.66 | 0.07 | 0.04 | 0.43 | 0.36 | 0.25 |
| CI (95%) | 5.498–5.507 | 5.76–5.81 | 4.76–4.93 | 3.515–4.728 | 5.734–5.865 | 4.735–4.808 | 3.917–4.712 | 5.145–5.812 | 4.33–4.79 |
| Shapiro–Wilk W | 0.6004 | 0.6004 | 0.9202 | 0.8933 | 0.7103 | 0.7693 | 0.8145 | 0.7086 | 0.801 |
| p-value (Mann–Whitney: Case 1 vs. Control) | 0.00169 | 0.3115 | 0.1122 | ||||||
| p-value (Mann–Whitney: Case 2 vs. Control) | 0.001649 | 0.023 | 0.02018 | ||||||
Publisher’s Note: MDPI stays neutral with regard to jurisdictional claims in published maps and institutional affiliations. |
© 2022 by the authors. Licensee MDPI, Basel, Switzerland. This article is an open access article distributed under the terms and conditions of the Creative Commons Attribution (CC BY) license (https://creativecommons.org/licenses/by/4.0/).
Share and Cite
Afonyushkin, V.N.; Akberdin, I.R.; Kozlova, Y.N.; Schukin, I.A.; Mironova, T.E.; Bobikova, A.S.; Cherepushkina, V.S.; Donchenko, N.A.; Poletaeva, Y.E.; Kolpakov, F.A. Multicompartmental Mathematical Model of SARS-CoV-2 Distribution in Human Organs and Their Treatment. Mathematics 2022, 10, 1925. https://doi.org/10.3390/math10111925
Afonyushkin VN, Akberdin IR, Kozlova YN, Schukin IA, Mironova TE, Bobikova AS, Cherepushkina VS, Donchenko NA, Poletaeva YE, Kolpakov FA. Multicompartmental Mathematical Model of SARS-CoV-2 Distribution in Human Organs and Their Treatment. Mathematics. 2022; 10(11):1925. https://doi.org/10.3390/math10111925
Chicago/Turabian StyleAfonyushkin, Vasiliy N., Ilya R. Akberdin, Yulia N. Kozlova, Ivan A. Schukin, Tatyana E. Mironova, Anna S. Bobikova, Viktoriya S. Cherepushkina, Nikolaj A. Donchenko, Yulia E. Poletaeva, and Fedor A. Kolpakov. 2022. "Multicompartmental Mathematical Model of SARS-CoV-2 Distribution in Human Organs and Their Treatment" Mathematics 10, no. 11: 1925. https://doi.org/10.3390/math10111925
APA StyleAfonyushkin, V. N., Akberdin, I. R., Kozlova, Y. N., Schukin, I. A., Mironova, T. E., Bobikova, A. S., Cherepushkina, V. S., Donchenko, N. A., Poletaeva, Y. E., & Kolpakov, F. A. (2022). Multicompartmental Mathematical Model of SARS-CoV-2 Distribution in Human Organs and Their Treatment. Mathematics, 10(11), 1925. https://doi.org/10.3390/math10111925

